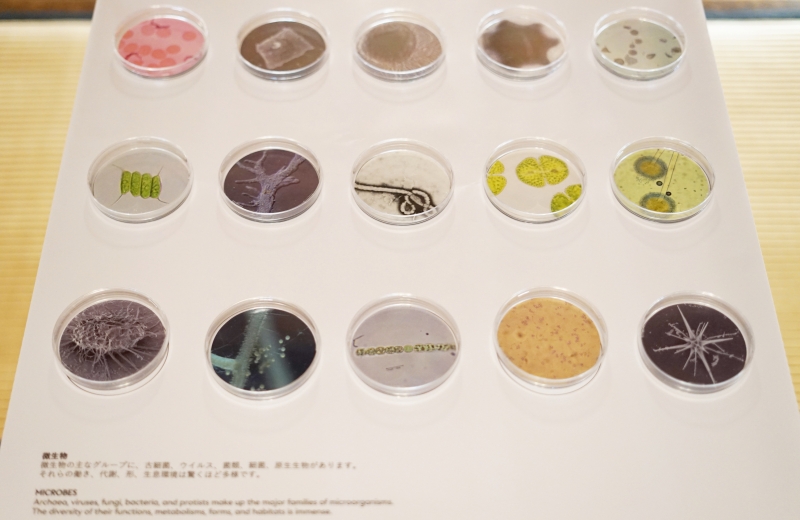

千葉県松戸市で始まった「科学と芸術の丘 2025」は、少し不思議な響きを持つイベントです。
“科学”と“芸術”、一見まったく違う世界をつなぎ合わせるという発想に、どこか未来の松戸を感じさせます。
会場となる戸定邸や松雲亭などの歴史ある空間には、国内外のアーティストや研究者が集い、AIや微生物、環境、音といったテーマをもとに多彩な展示を行っています。アルスエレクトロニカやスイス大使館など国際的な機関との共同展示もあり、日常ではなかなか触れることのない“科学とアートの交差点”を体感できる内容です。
今年のテーマは「Delta of Creativity − 創造のΔ −」。
AIで記憶を再構築するプロジェクトや、身体の反応をデジタルアートに変える体験型展示、都市に生きるネズミの生態を科学の視点から見つめる作品など、ジャンルを越えた試みが並びます。
科学の冷たさと、芸術のあたたかさ。その両方を行き来するような3日間が、松戸のまちを舞台に広がっています。
科学とアートが交差する松戸の3日間

千葉県松戸市で開催されている「科学と芸術の丘 2025」は、今年で7回目を迎えます。
戸定邸や松雲亭、戸定が丘歴史公園など、歴史的建造物が点在するエリアを舞台に、科学・芸術・自然という異なる分野をつなぐ試みが広がっています。会期は10月24日から26日までの3日間。秋のやわらかな光が差し込む庭園の中で、世界各地のアーティストや研究者の作品が静かに共鳴します。

今年のテーマは「Delta of Creativity − 創造のΔ −」。
“Δ(デルタ)”は変化や差異を象徴する記号であり、「異なるものが交わるところに新しい創造が生まれる」という意味が込められています。科学の論理性と芸術の感性、そして自然の持つ偶然性。その三つが交差する瞬間こそ、人間の想像力がもっとも豊かに広がる場であるという考え方です。
特徴的なのは、国際的なつながりの広がりです。
在日スイス大使館・科学技術部やオーストリア文化フォーラムが協力し、スイスやオーストリアの研究機関・アーティストとの共同展示が実現しました。さらに、世界的メディアアート機関として知られる「アルスエレクトロニカ」との共同キュレーションによって、AIやデジタル技術を用いた先端的な作品も展示されます。
新たに加わった松戸中央公園では、屋外展示やワークショップ、マルシェなど、市民が気軽に参加できる企画も多く用意されています。
戸定邸の静謐な空間と、街の中心にある公園。その対照的な場をつなぐように、アートとサイエンスが流れる3日間です。
科学が語るアート、アートが映す科学
会場に並ぶ作品はどれも、科学的なテーマを扱いながらも“実験室”というより“詩”のように静かに問いかけてきます。
スイスと日本の共同プロジェクトでは、微生物を題材にした研究とアートが融合しました。人の目には見えない生命の営みを、サイエンスと市民参加の形で可視化する試みです。スイス国立研究拠点とローザンヌの美術館が手がけた展示では、微生物が環境や人体にもたらす多様な働きを紹介し、来場者が自分の暮らしと自然の関わりを考えるきっかけを与えます。

テクノロジーの先端を体感できるのが、世界的なメディアアート機関「アルスエレクトロニカ」による展示です。
ワコムやTOAと共同開発した《Life Ink Community》は、バイオセンサーを装着した参加者の脳波や筋電を“デジタルインク”として可視化するインタラクティブ作品。ペンを持たずに、身体そのものを“描く道具”に変える発想は、アートと科学の境界を越える象徴的な試みです。サウンドと映像が連動し、身体の反応が音として響く仕組みは、感性とテクノロジーが共鳴する瞬間を見せてくれます。

また、東京大学の研究者と写真家が協働した《Rats in the City(都市のネズミ)》では、都市の片隅に生きるネズミを科学とデザインの視点で再発見します。
3Dスキャンによる巣の立体模型や、フェロモンの香りを再現した展示など、科学的データとアート的感性の両面から「人と都市と生物の共存」を問いかける内容です。日常の中に潜む生命のリアリティを、アートがそっと浮かび上がらせています。
市民がつくる“創造の場”として

「科学と芸術の丘」の最大の特徴は、アーティストや研究者だけでなく、市民も主役になっていることです。
イベントの運営や展示づくりには地元の人々が深く関わり、松戸というまち全体が“創造の場”として機能しています。アートを「鑑賞するもの」ではなく、「ともにつくるもの」として位置づけている点に、このフェスティバルの独自性があります。
ディレクターの岩澤哲野氏は、「異なる分野や立場の人が交わることで、新しい発想が生まれる」と語ります。テーマである“Δ(デルタ)”が示すように、単一の答えや正解を求めるのではなく、異なる視点のあいだにこそ創造の芽があるという考え方です。戸定が丘の自然と歴史、街のカフェやショップ、研究機関や学生たち。そのすべてが混ざり合い、まち全体が一つのアート作品のように息づいています。

もう一人のディレクター、海野林太郎氏は、戸定邸という空間の特性に注目します。
「外と中の境界があいまいな建築だからこそ、風や鳥の声、光といった自然の気配が作品と溶け合う」と語り、展示空間そのものを“生きた装置”として捉えています。
デジタルアートやAI作品であっても、この場所に置かれることで、単なる技術展示ではなく、人と自然が呼応する表現に変わっていく――そんな松戸ならではの文脈が、フェスティバル全体を包んでいます。
さらに今年は、相模台エリアの「松戸中央公園」も新会場として加わりました。
緑に囲まれた公園では、子どもや家族連れが体験できるワークショップや、地元クリエイターによるマルシェが開かれています。専門的な知識がなくても誰もが“創造のΔ”を体感できるように設計されており、研究者やアーティストと市民が自然に交わる空間が生まれています。
この「市民がつくるフェスティバル」という在り方こそ、科学と芸術を“日常の中に戻す”試みと言えるでしょう。
創造の芽吹く丘へ

「科学と芸術の丘 2025」は、科学の知とアートの感性をつなぎ合わせ、人と自然、都市と創造の関係を見つめ直す3日間です。
展示やワークショップを通して描かれるのは、答えのない問いを受け入れるための“余白”のような時間。
AIや微生物、都市の生態系など、一見難しそうなテーマも、作品を通して驚くほど身近に感じられます。
それぞれの展示は、観る人に「自分ならどう考えるだろう」と静かに問いかけてきます。
科学がつくるデータの世界と、芸術が見つめる感情の世界。
そのあいだにあるわずかな隙間に、未来をつくる創造の芽が息づいているのかもしれません。 秋の光が降り注ぐ戸定の丘で、科学と芸術、そして人と自然が交わる瞬間に触れてみてはいかがでしょうか。
科学と芸術の丘 2025 概要
会期: 2025年10月24日(金)〜26日(日)
時間: 10:00〜16:30(最終日は16:00まで)
会場: 千葉県松戸市(戸定邸・松雲亭・戸定が丘歴史公園・松戸中央公園 ほか)
料金: 一般1,000円/高校生・大学生900円/市民割500円(中学生以下無料)
公式サイト:https://science-art-matsudo.net/